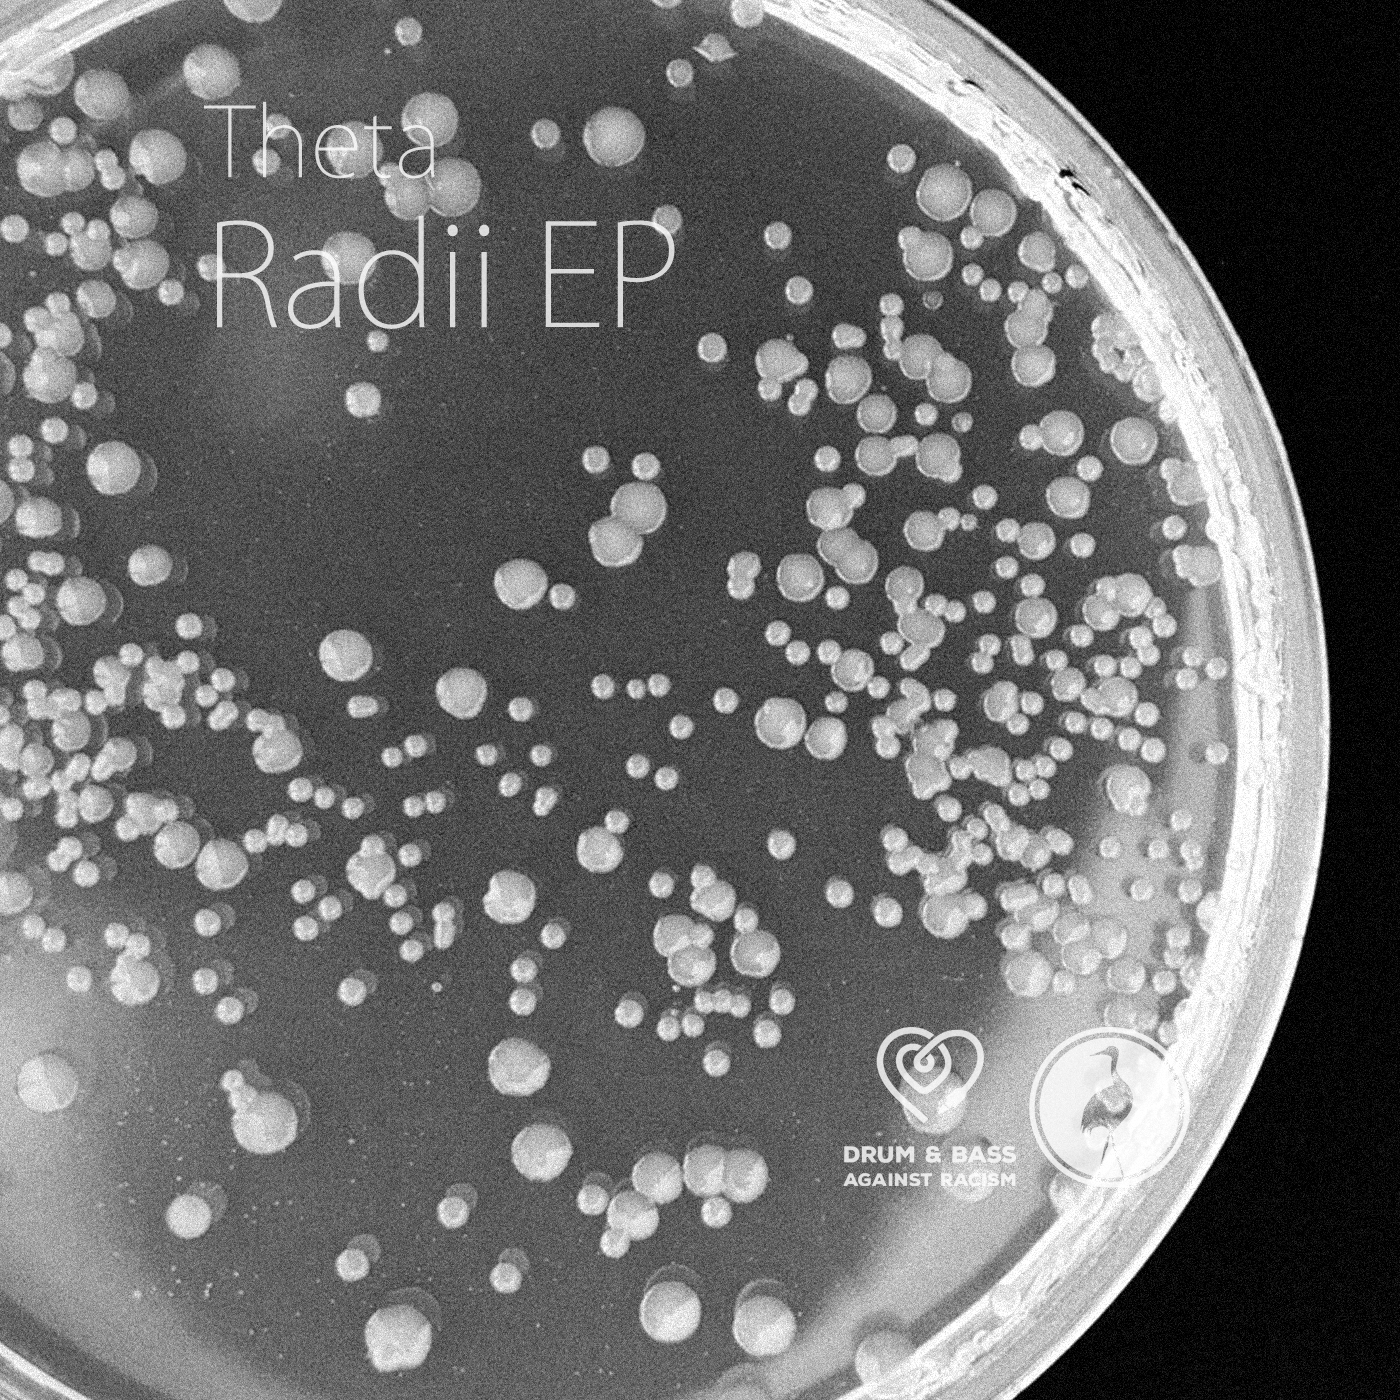

Radii EP by Theta
Tracklist
| 1. | Centrepoint | 6:42 |
| 2. | Cusp | 7:09 |
| 3. | Periphery | 6:07 |
| 4. | Full Circle | 5:05 |
Credits
released April 16, 2018
mastering: LXC
Cusp video: www.lookmaitmoves.com
www.facebook.com/thetadnb/
soundcloud.com/theta_dnb
www.facebook.com/blackcranelabel/
soundcloud.com/blackcranelabel
mastering: LXC
Cusp video: www.lookmaitmoves.com
www.facebook.com/thetadnb/
soundcloud.com/theta_dnb
www.facebook.com/blackcranelabel/
soundcloud.com/blackcranelabel